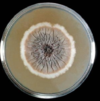

Esporotricose Flashcards
1
Q

A
1- S. schenckii
cultura miceliana → parece algodão
2
Q

A
2- S. schenckii
cultura leveduriforme → aspecto de bactéria
3
Q

A
3- S. schenscki
cotonoso, leveduriforme e forma micelial
4
Q

A
4- S. schenscki
dimorfismo
5
Q

A
5- S. schenscki
Gram +
6
Q
A
6- S. schenscki
Cultura 25º → Cotonoso
Enrugadas
Acaastanhado / Enegrecido
7
Q

A
7- S. schenscki
Micromorfologia (Margarida)
8
Q

A
8- S. schenscki
Micromorfologia 37º
Forma Charuto (esféricas / oval / alongada)
9
Q

A
9- S. schenscki
Micromorfologia 25º
10
Q

A
S. schenckii
Cultura 37°C → levedura
Colônias Úmidas e Cremosas
Coloração Amarelada